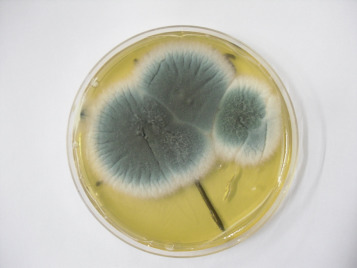
1-s2.0-S1557506315000798-gr4

- El zorro rojo como mascota
- Poliuria y polidipsia en hurones
- Guia para sexar periquitos
- Dudas más frecuentes en tortugas de agua
- Las aves de canto
- Antiparasitarios en animales exóticos
- Alteraciones vitaminicas en rapaces
- Manejo veterinario de una nurseria de aves rapaces
- Cosas que no debes hacer delante de tu loro
- Cuidados del sapo vientre de fuego (Bombina orientalis)
Aspergillosis en cetreria
No son pocos los cetreros que tiemblan con la palabra «aspergillosis» sobre todo cuando su colección la componen halcones gerifaltes de unos cuantos miles de euros.
Y es que la aspergillosis es una enfermedad causada por un hongo oportunista, el Aspergillus spp que puede causar estragos en centros de cría y colecciones privadas, ya que su mortalidad es muy elevada. Las especies más afectadas por este hongo son el halcón gerifalte (Falco rusticolus) el buho nival (Nyctea scandiacea), el azor (Accipiter gentilis)el ratonero calzado (Buteo lagopus), el águila real (Aquila chrysaetos) águilas pescadoras, quebrantahuesos juveniles y en general las especies árticas o de climas subárticos. Sin embargo, otras especies como el águila de harris o el cernicalo común parecen más resistentes a la enfermedad, aunque en situaciones de debilidad o inmunosupresión severa también pueden verse afectadas.
El hongo implicado suele ser A. fumigatus, pero hay otras especies que también pueden desarrollar el cuadro como A. nigricans o A. glaucus entre otras). Por desgracia las pruebas diagnosticas estan encaradas a buscar a A. fumigatus por lo tanto, esto puede dificultar el diagnostico cuando otra especie es la que está implicada.
La vía de infección más frecuente es la inhalación, siendo los órganos más gravemente afectados el respiratorio inferior (pulmones, sacos aéreos). Cuando las esporas colonizan el sistema respiratorio, pueden migrar hacia la cavidad celómica pudiendo contaminar cualquier órgano en ella. Es por ello, que puede haber afección cardiaca, renal, hepática e incluso neurológica. El hongo también puede colonizar epitelios dañados y mucosas, como la córnea o la piel.
La aspergillosis no es una enfermedad contagiosa, sino una infección ambiental en la cual hay muchos factores implicados. Para que la infección ocurra es necesaria la presencia de esporas en el ambiente, y eso es más común en lugares húmedos, poco ventilados, sucios, con presencia de heno o otra materia vegetal en mal estado o presencia de restos de comida y heces acumulados. En el caso de los polluelos, nidos con mucha suciedad o un sustrato inadecuado como viruta de madera también pueden favorecer el crecimiento del hongo. Eso en combinación a estrés o otros factores que inmunosupriman al ave da como resultado una infección aguda. Algunos de estos factores son captura reciente (en aves silvestres o aves que se han escapado), cambio de propietario/cesión, aves muy jóvenes o por el contrario muy viejas, aves que reciben tratamientos con córticos, aves que están en contacto continuo con irritantes respiratorios como el humo de tabaco, humo de vehiculos, productos químicos etc. Y aves intoxicadas por plomo. A pesar de todo esto, se han observado también casos de aspergillosis en aves aparentemente sanas mantenidas en buenas condiciones por razones desconocidas.
Existen tres formas de aspergillosis: aguda, crónica y localizada.
Forma aguda
Se trata de una exposición a una gran cantidad de esporas fúngicas en un periodo muy corto de tiempo. Esto suele ocurrir en aves que se alojan de forma temporal o momentánea en zonas muy sucias, poco ventiladas y con una elevada humedad ambiental con elementos tales como balas de heno, pinaza, hojas secas, alfombras etc. En estos casos la enfermedad es de desarrollo muy rápido y las especies susceptibles pueden morir en apenas unos dias, ya que las esporas colonizan una parte muy extensa de su organismo. Esto también puede ocurrir en mudas muy sucias y mal ventiladas, con hojas acumuladas en el suelo que son limpiadas sin sacar a las aves de las mismas, levantando una nube de esporas al barrerlas que infectará a nuestros halcones de forma aguda.
Forma crónica
En este caso, pequeñas infestaciones del hongo que se van extendiendo poco a poco en el organismo del ave. Suele afectar a especies menos sensibles que muestran una sintomatologia infespecifica y el hongo puede ser encontrado en cualquier órgano del cuerpo. En esta forma de infección, la immunosupresión juega un papel importante. Aves estresadas, en ambientes donde hay presencia de otras rapaces o otros animales, mudas muy pequeñas, presencia de gente desconocida de forma constante, ruidos estridentes, etc.
Infección en el halcón gerifalte
Le dedicamos un capítulo aparte por la gravedad y el impacto socio-económico que tiene esta enfermedad en la cetrería. En los gerifaltes se puede ver un cuadro que consiste en la manifestación de la enfermedad cuando el ave tiene aproximadamente unas 10 semanas de vida y que suele causarles la muerte. Aquí las a
ves son criadas con esmero, en áreas limpias y libres de estrés por lo que lo comentado anteriormente no es aplicable en este caso. La causa exacta de esta infección no es conocida, pero se baraja la posibilidad de que los gerifaltes juveniles no tengan inmunidad frente al Aspergillus spp. Otra teoría es que estas aves sufran estrés debido a las elevadas temperaturas de nuestro clima (áreas donde más observamos estas infecciones) a finales de Julio y Agosto que según varios autores es cuando más casos se observan o también se baraja la posibilidad de otros factores que estresen a esta especie y seamos incapaces de detectar. Otra posible explicación es que un virus hasta ahora desconocido, actué de forma conjunta con el hongo, es decir debilite al pájaro y este sea afectado de forma oportunista por el aspergillus.
Los híbridos de gerifalte con otras especies (como halcón sacre o especies de peregrinos de climas templados) aparentemente son más resistentes a la infección y por ello son apreciados en la cetrería de zonas más cálidas y desérticas.
Es necesario abrir una línea de investigación para determinar porque estas aves suelen verse tan frecuentemente afectadas por esta infección.
La sintomatología de la enfermedad es muy variada, ya que el hongo puede afectar cualquier órgano del cuerpo. Pero en una fase inicial lo que observaremos es una sintomatologia inespecífica que puede también ser de cualquier otra enfermedad como:
– reducción de la actividad, del acicalamiento, el ave tiene un aspecto sucio y despeinado.
– aves inactivas, adormiladas y que bajan al suelo con mucha frecuencia.
– anorexia parcial. El ave toma con energía y interés la comida, pero posteriormente no la consumen sino que la mantienen agarrada con las garras o la desmenuzan un poco sin llegar a consumirla. Si ofrecemos picadas, las cogerá con interés pero no las tirará.
– falta de energía al volar, se posan rápidamente a tomar aire, respiración agitada al hacer poco ejercicio. No son capaces de perseguir a las presas.
– cambios en la voz.
– Signos respiratorios y pérdida de peso (esto son síntomas de enfermedad ya avanzada).
El diagnostico de la aspergillosis no es fácil. La visita al veterinario es indispensable si lo que se quiere es diagnosticar la enfermedad y poder salvar al animal.
La batería de pruebas diagnosticas incluye lo siguiente:
* Signos clínicos, especialmente si se trata de una especie sensible o no, época del año, edad del animal etc.
* cultivo de muestra traqueal o lavado de los sacos aéreos.
* serologia ELISA (solo válido para A. fumigatus)
* hemograma (se observará leucocitosis, heterofilia con heterófilos tóxicos, monocitosis)
* Proteinograma (son caracteristicas los aumentos de las betta y gamma globulinas)
*endoscopia. En los casos donde la sintomatologia está muy clara, nos puede dar un diagnostico definitivo. Se pueden observar las lesiones en tráquea o en sacos aéreos.
*estudio radiologico. Es una herramienta muy limitada, no siempre se observan las lesiones en las radiografias.
En casos iniciales, endoscopicamente podemos observar sacos áereos inflamados y vascularizados. Esto no es patognomónico de la aspergillosis, pero si observamos esa lesión debe estar en el diagnostico diferencial.
La prueba de elección es sin duda el ELISA. Podemos determinar si el ave tiene anticuerpos contra el patógeno con esa prueba diagnostica. Pero por desgracia tiene sus limitaciones, ya que puede estar afectada por otra especie de Aspergillus diferente al fumigatus o puede ser un ave muy inmunosuprimida la cual no tenga anticuerpos para ser detectados.
El tratamiento para la aspergillosis es muy limitado y por desgracia no siempre funciona bien. Hay diversos antifungicos, como la Anfotericina B, el clotrimazol y el itraconazol que pueden emplearse para combatir la infección, especialmente cuando se hacen combinaciones con ellas. La posologia es muy variada y puede ser intratraqueal, intravenosa y nebulizada. Actualmente se ha observado que el voriconazol funciona bastante bien.
El tratamiento con antifúngicos siempre debe prescribirlo un veterinario, dado que es necesario hacer combinaciones con varios de ellos y por diversas vías de administración y todo esto puede variar según la especie, estado físico y edad del animal afectado.
El pronóstico depende de la sintomatologia que presenta el ave y se divide en 4 clases:
Clase I
Animales con sintomatologia inespecifica, sin imagen endoscopica de aspergillosis, pero analitica compatible el tratamiento con itraconazol o voriconazol suele dar un muy buen pronóstico.
Clase II
Aves con síntomas respiratorios, cultivo positivo y inflamación de los sacos aéreos visible en la endoscopia. Con el mismo tratamiento descrito arriba el pronóstico también suele ser bueno.
Clase III
Aves con sintomatologia respiratoria severa junto con anorexia y otros síntomas asociados. Cultivo positivo, serologia negativa o positiva ténue. Lesiones visibles por endoscopia. En este caso se deben retirar las lesiones con cirugía (ablación con láser) y hacer un tratamiento agresivo. El pronóstico es malo en azores y reservado en halcones.
Clase IV
En esta clasificación incluimos aquellas aves cuya afección está en el sistema respiratorio superior (traquea). En algunos casos es posible la eliminación quirúrgica de la lesión y el tratamiento es mediante anfotericina B intratraqueal. En estos casos el pronóstico también suele ser muy bueno.
Como en todas las patologias lo mejor es la prevención.
– Tener las mudas con un buen sistema de ventilación y evitar que se acumule materia orgánica vegetal.
– No almacenar heno o leña en las cercanias de las mudas
– Limpiar las mudas sacando al ave de las mismas
– tratamiento profiláctico con itraconazol en aves sensibles procedentes de exportaciones y pichones entre 45 y 90 días de vida especialmente en climas cálidos. Esto es controvertido, ya que se desconoce si podría acarrear resistencias. Hay que tener en cuenta que los gerifaltes solo toleran dosis bajas de este fármaco (8 mg/kg máximo).
– Desinfección con F10 las instalaciones de forma periódica.

You must be logged in to post a comment Login